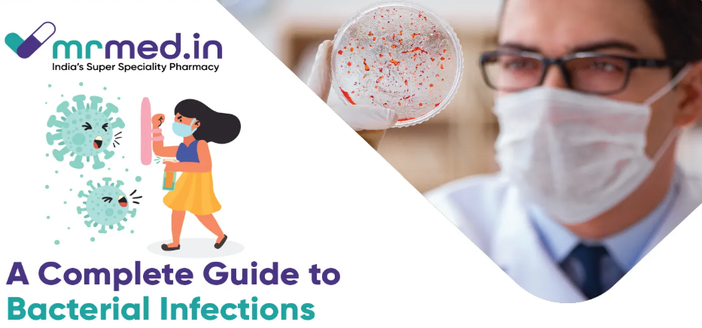

How ancient viruses could help fight antibiotic resistance
#Health #Bacteria #Antibiotics #PhageTherapy #Phages #AntibioticResistance #AMR #Microbiology #Superbugs #InfectiousDiseases #BacteriaVsVirus #MedicalResearch #PublicHealth
https://the-14.com/how-ancient-viruses-could-help-fight-antibiotic-resistance/
#Health #Bacteria #Antibiotics #PhageTherapy #Phages #AntibioticResistance #AMR #Microbiology #Superbugs #InfectiousDiseases #BacteriaVsVirus #MedicalResearch #PublicHealth
https://the-14.com/how-ancient-viruses-could-help-fight-antibiotic-resistance/